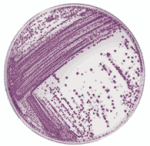

|
RAPID'沙門氏菌的的快速培養(yǎng)基檢測
|
| |
|
AFNOR-approved in compliance with ISO16140,
AOAC-RI validation pending.
|
Intended Use
RAPID'Salmonella is a chromogenic medium for the
detection of Salmonella spp. in the analysis of
food products for human and animal consumption. |
| |
| |
|
 |
RAPID'沙門氏菌檢測試劑盒的原理
|
| |
The principle of the RAPID'Salmonella medium
is based on the demonstration of two enzymatic activities.
Salmonella take the form of readily identifiable, typical
magenta colonies (detection of C8 esterase). Counterselection
is used to reveal other bacteria with a different color.
RAPID'Salmonella can be used to detect motile and nonmotile
Salmonella, as well as lactose-positive Salmonella, Salmonella
Typhi, and Salmonella Paratyphi. |
 |
RAPID'沙門氏菌檢測試劑盒的特點
|
| |
 |
Economical and Easy-to-Use: 2 broths, 1 plate |
 |
Fast: Results in as little as 48 hr, and Alternative confirmation in 1 hr |
 |
Highly sensitive With
Good specificity and selectivity: Detection
of motile and nonmotile Salmonella, lactose-positive,
Salmonella Typhi and Salmonella |
 |
Easy-to-Read: Magenta colonies are Salmonella spp. |
| |
 |
 |
RAPID'沙門氏菌檢測實驗所需試劑
|
| |
|
產(chǎn)品編號 |
產(chǎn)品描述 |
| 356-3961 |
RAPID'Salmonella Medium,90 mm x 20 dishes |
|
356-4705 |
RAPID'Salmonella Medium,500 g |
|
356-4706 |
RAPID'Salmonella Medium,100 g |
|
 |
RAPID'沙門氏菌檢測實驗方法
|
| |
After overnight pre-enrichment in buffered
peptone water (18 + 2 hr), followed by selective enrichment
in Rappaport-Vassiliadis soy (RVS) broth with an incubation
time of between 6 and 26 hr, the RAPID'Salmonella chromogenic
medium is inoculated with 10 µl of the RVS broth. An alternative
confirmation is also validated in the RAPID'Salmonella protocol
and gives results in 1 hr. |
 |
RAPID'Salmonella can also be used as a second medium
in the ISO6579 standard
|
 |
在線產(chǎn)品樣本(PDF格式) |
|